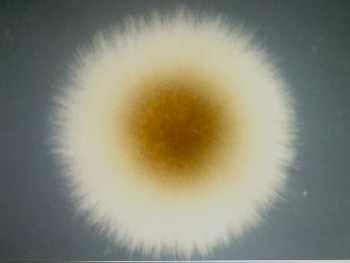

|
|
| Scanning electron micrograph of a Mycobead showing surface
details, confirming no presence of fungal mycelium exterior to the bead.
|
|
|
| Scanning electron micrograph of a Mycobead after the hydrogel
material was removed by dissolution. The fungal mycelium is revealed to be throughout the
bead and just underneath the surface of the bead.
|
|
|
| A higher magnification scanning electron micrograph of a Mycobead
with the hydrogel material removed. The mycelium is revealed to be comprising intact and
unfragmented hyphae.
|
| Outgrowth of Fungi from Mycobead
While it is desirable to keep the fungus immobilized within the beads during culture and all stages prior to use as inoculum, ultimately, the fungus has emerge from the beads after inoculation to form mycorrhizal associations with the roots of inoculated seedlings. |
|
|
| A darkfield view of Laccaria laccata mycelium emerging from a Mycobead
three days after incubation on an agar plate.
|
|
|
| Pisolithus tinctorius mycelium emerging from a Mycobead
three days after incubation on an agar plate.
|
| Initiation of Mycorrhiza by Mycobead
The mycelium which emerges from Mycobead has to be capable of initiating mycorrhiza on the roots of host plants.
|
|
|
| The formation of mycorrhiza on a eucalypt seedling 10 days after
inoculation with Mycobead. The test system used was an agar plate.
|
|
|
| Root of a eucalypt seedling 11 weeks after inoculation with Mycobead. Evident are the remnant of a bead, fungal mycelium attached to roots, and an ectomycorrhiza (club root structure, indicating that the inoculation was successful). The test system used was yellow sand potting mix in a glasshouse. |